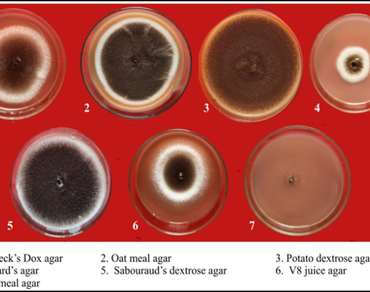
n                     Aspergillus nigern                  , Collar rot, Fungicide efficacy, Biological control, n                     Trichoderma harzianumn

Cultural, morpho-molecular characterization of Aspergillus niger associated with collar rot of groundnut (Arachis hypogaea L.) and in-vitro evaluation of fungicides and bioagents
*Article not assigned to an issue yet
Dani Padma Priya, Huded Sharanabasav, Kalappanavar Ishwar K, Kulkarni Shripad
Research Articles | Published: 30 March, 2026
First Page: 0
Last Page: 0
Views: 86
Keywords: n Aspergillus nigern , Collar rot, Fungicide efficacy, Biological control, n Trichoderma harzianumn
Abstract
Aspergillus niger, a predominant seed-borne pathogen, causes collar rot in groundnut resulting in reduced seed germination and seedling vigour. This study involved the cultural, morphological, and molecular characterization of A. niger, along with in vitro evaluation of fungicides, and bioagents for its effective management in two different methods. Among seven tested culture media, the highest radial growth of A. niger was recorded on Potato Dextrose Agar (90.33 mm), followed by V8 Juice Agar (88.33 mm). Microscopically, pathogen exhibit septate, hyaline hyphae with conidiophores terminating in globose black conidial heads. Molecular identification of present study isolate i.e. GN-ITS-UASD using multi-locus sequencing confirmed isolate as A. niger and obtained NCBI accession number’s PV865284 and PX149243 for ITS and RPB2 respectively. Multilocus concatenated (ITS + RPB2) phylogeny confirmed that isolate from groundnut seed origin i.e. GN-ITS-UASD is a true A. niger lineage, clustering strongly with global reference strains. Among systemic fungicides, tebuconazole found most effective (13.56% infection, 82.67% germination, with vigour index of 3058.91). Captan was the best-performing non-systemic fungicide, shown 11.11% infection and a vigour index of 3172.90. Carboxin + Thiram and Trifloxystrobin + Tebuconazole were the most effective combi fungicides. Among bioagents, Trichoderma harzianum showed the highest suppression (17.33% infection, 76.84% mycelial inhibition). Overall, the integration of effective fungicides particularly tebuconazole, captan, and carboxin + thiram along with T. harzianum offers a promising strategy for the management of collar rot disease and improvement of groundnut seedling health under in vitro conditions.
References
Adithya G (2016) Effect of Aspergillus flavus on groundnut seed quality and its management. PhD thesis, Professor Jayashankar Telangana State Agricultural University. https://oar.icrisat.org/9725/
Aiswarya N, Bhattiprolu SL, Reddy BK, Rao RG (2024) Effect of Aspergillus spp. on seed quality characters of groundnut. Indian J Agric Res 58(2):306–312. https://doi.org/10.18805/IJARe.A-5683
Ayesha MS, Suryanarayanan TS, Nataraja KN, Prasad SR, Shaanker RU (2021) Seed treatment with systemic fungicides: time for review. Front Plant Sci 12:654512. https://doi.org/10.3389/fpls.2021.654512
Bian C, Visagie CM, Liao HL, Oakley B, Peterson SW, Samson RA (2022) Reducing the number of accepted species in Aspergillus series Nigri. Persoonia 48:110–139. https://doi.org/10.3767/persoonia.2022.48.04
Bliss CL (1934) The method of probits. Science 79:38
Brar AS, Manhas SS (2023) Effect of gypsum, nitrogen and phosphorus on growth, yield and quality of spring groundnut. Legume Res 46(11):1483–1489. https://doi.org/10.18805/LR-5126
Ceresini PC, Silva TC, Vicentini SNC, Júnior RPL, Moreira SI, Castro-Ríos K, de Jesus Júnior WC (2024) Strategies for managing fungicide resistance in the Brazilian tropical agroecosystem. Trop Plant Pathol 49(1):36–70. https://doi.org/10.1007/s40858-023-00632-2
Charitha Devi M, Prasad RD (2009) Biointensive management of collar rot of groundnut caused by Aspergillus niger. J Biol Control 23(1):21–24. https://doi.org/10.18311/jbc/2009/3610
Chavda HC, Diwan S, Prajapati BK, Brahmbhatt AB (2016) Molecular characterization of Aspergillus niger Van Tieghem isolates using RAPD markers. Mycology 7(3):181–189. https://doi.org/10.18805/ag.D-5994
Corkley I, Fraaije B, Hawkins N (2022) Fungicide resistance management: maximizing the effective life of plant protection products. Plant Pathol 71(1):150–169. https://doi.org/10.1111/ppa.13467
Das S, Dash HR, Mangwani N, Chakraborty J, Kumari S (2014) Understanding molecular identification and polyphasic taxonomic approaches. J Microbiol Methods 103:80–100. https://doi.org/10.1016/j.mimet.2014.05.013
El-Wakil EA (2001) Chemical studies of selected plants and their evaluation as molluscicides. PhD thesis, Ain Shams University, Egypt
Eti YAA (2022) Evaluation of selected culture media for growth and sporulation of Alternaria isolate causing grey blight of mustard and its molecular characterization. MSc thesis, Sher-e-Bangla Agricultural University. http://archive.saulibrary.edu.bd:8080/xmlui/handle/123456789/4975
Ezeonuegbu BA, Machido DA, Yakubu SE (2014) Resistance to heavy metals among fungal flora of refinery effluent. J Appl Sci Environ Manage 18(4):623–627. https://doi.org/10.4314/jasem.v18i4.10
FAOSTAT (2023) Food and Agriculture Organization of the United Nations. https://www.fao.org/faostat/
George A, Jeeva ML, Nath VS, Sreelatha GL, Sujina MG (2018) Efficient genomic DNA extraction protocol for Phytophthora colocasiae. Arch Phytopathol Plant Prot 51(5–6):241–251. https://doi.org/10.1080/03235408.2018.1460914
Hall TA (1999) BioEdit: a user-friendly biological sequence alignment editor. Nucleic Acids Symp Ser 41:95–98
Houbraken J, Samson RA (2011) Phylogeny of Penicillium and segregation of Trichocomaceae. Stud Mycol 70:1–51. https://doi.org/10.3114/sim.2011.70.01
Jeyakumar P, Boominathan P (2016) Combined effect of trifloxystrobin and tebuconazole on growth and yield attributes of groundnut. Legume Res. https://doi.org/10.18805/lr.v0iOF.6773
Kameswara Rao N, Dulloo ME, Engels JM (2017) Factors influencing production of quality seed for long-term conservation. Genet Resour Crop Evol 64(5):1061–1074. https://doi.org/10.1007/s10722-016-0425-9
Khan MS, Sharma V, Mehta N, Ansari MA (2018) Influence of culture media on seed-borne fungi in pulses. J Mycol Plant Pathol 48(1):106–110
Kiri AS, Zakari BG, Jimeta GZ, Isa A (2023) Postharvest management of fungal rot of groundnut using neem leaf extracts. Asian Plant Res J 11(3):13–21
Kumar CV, Saifulla M, Reddy MG, Naveenkumar R, Prabhukarthikeyan SR (2020) Occurrence, pathogenicity and assessment of groundnut genotypes resistance to Aspergillus niger inciting collar rot disease. Int J Curr Microbiol Appl Sci 9(11):874–886. https://doi.org/10.20546/ijcmas.2020.911.105
Kumar S, Stecher G, Suleski M, Sanderford M, Sharma S, Tamura K (2024) MEGA12: molecular evolutionary genetics analysis version 12 for adaptive and green computing. Mol Biol Evol 41(12):msae263. https://doi.org/10.1093/molbev/msae263
Kumar V, Thirumalaisamy PP, Indian Phytopathological Society (2016) Diseases of groundnut. Disease of field crops and their management. Today and Tomorrow’s Printers and Publishers, New Delhi, pp 459–487
Mahadevi C SS (2020) Bio-efficacy of bio-agents against Aspergillus niger inciting collar rot in groundnut (Arachis hypogaea L). J Oilseeds Res. https://doi.org/10.56739/jor.v37iSpecialissue.141064
Martín I, Gálvez L, Guasch L, Palmero D (2022) Fungal pathogens and seed storage in the dry state. Plants 11(22):3167. https://doi.org/10.3390/plants11223167
Mohapatra KB, Sahoo MK (2011) Pathogenicity and biocontrol of Aspergillus niger the causal agent of seed and collar rot of groundnut
Murray MG, Thompson WF (1980) Rapid isolation of high molecular weight plant DNA. Nucleic Acids Res 8:4321–4325
Nandeesha BS, Redi M, Reddy ENP (2013) Evaluation of fungicides and compatibility with Trichoderma spp. for managing collar rot of groundnut. Asian J Biol Life Sci 2(1):59–63
Nath K, Patel VP (2022) Evaluation of different fungicides and bio-agents to minimize the collar rot disease of groundnut caused by Aspergillus niger Van Tiegham
Nathawat BDS, Partap M (2014) Evaluation of fungicides, botanicals and Trichoderma spp. against collar rot of groundnut. Ann Plant Protect Sci 22:382–385
Nilsson RH, Larsson KH, Taylor AFS et al (2008) Intraspecific ITS variability in fungi: implications for molecular identification. Evol Bioinform 4:193–201
Padma Priya D, Huded S, Kalappanavar IK, Harish J, Kulkarni S, Tippannavar PS (2025) Comparative analysis of prevalence and morpho-molecular diversity of major seed-borne fungal contamination in groundnut seeds from field and market sources in northern Karnataka, India. Physiol Mol Plant Pathol 103:103094. https://doi.org/10.1016/j.pmpp.2025.103094
Pitt JI, Hocking AD (2009) Fungi and food spoilage, 3rd ed. Springer, New York. https://doi.org/10.1007/978-0-387-92207-2
Prajapati BK, Patil RK, Chavda HC (2016) Molecular characterization of Aspergillus niger isolates inciting black mould of onion through RAPD. Int J Agric Environ Biotechnol 9(4):637–642. https://doi.org/10.5958/2230-732X.2016.00083.8
Raja HA, Miller AN, Pearce CJ, Oberlies NH (2017) Fungal identification using molecular tools: a primer for the natural products research community. J Nat Prod 80:756–770. https://doi.org/10.1021/acs.jnatprod.6b01085
Rajendra MGS, (2021) Morpho-physiological characterization of summer groundnut (Arachis hypogaea L.) Doctoral dissertation, Mahatma Phule Krishi Vidyapeeth.
Rajeshkumar KC, Yilmaz N, Marathe SD (2019) Morphology and multigene phylogeny of Talaromyces amyrossmaniae, a new synnematous species from India. MycoKeys 45:41–56. https://doi.org/10.3897/mycokeys.45.32549
Ramganesh S, Timothy S, Sudharshan S, Willem AJN (2019) Industrial effluents harbor unique fungal community structures revealed by high-throughput sequencing. Polish J Environ Stud 28(4):2353–2362. https://doi.org/10.15244/pjoes/90791
Rokas A, Williams BL, King N, Carroll SB (2003) Genome-scale approaches to resolving incongruence in molecular phylogenies. Nature 425:798–804. https://doi.org/10.1038/nature02053
Samson RA, Visagie CM, Houbraken J et al (2014) Phylogeny, identification and nomenclature of the genus Aspergillus. Stud Mycol 78:141–173. https://doi.org/10.1016/j.simyco.2014.07.004
Schoch CL, Seifert KA, Huhndorf S et al (2012) Nuclear ribosomal internal transcribed spacer (ITS) region as a universal DNA barcode marker for fungi. Proc Natl Acad Sci USA 109(16):6241–6246. https://doi.org/10.1073/pnas.1117018109
Sekhon HS, Singh M, Chawla S (2019) Management of collar rot in groundnut caused by Aspergillus niger. Legume Res 42(5):723–727
Shango AJ, N’Danikou S, Ramadhani S, Sumaye S, Nickas J, Daud ML (2024) Prevalence of seed-borne fungi on soybean seeds stored under medium-term cold room facilities. Seeds 3(4):589–607. https://doi.org/10.3390/seeds3040040
Sharanabasav H, Pramesh D, Prasannakumar MK et al (2021) Morpho-molecular and mating-type locus diversity of Ustilaginoidea virens from southern India. J Appl Microbiol 131(5):2372–2386. https://doi.org/10.1111/jam.15087
Sharma D (2012) Morphological and cultural variability in Aspergillus niger isolates. Int J Plant Prot 5(2):410–413
Sharma P, Saini M, Swati D, Vignesh K (2012) Biological control of groundnut root rot in farmers’ fields. J Agric Sci 4(8):48–59
Sharvelle EG (1961) The nature and uses of modern fungicides. Burgess Publishing Company, Minneapolis
Shivpuri A, Meena PD, Khanduri P, Meena RP (2011) Comparative performance of fungicidal seed treatments on groundnut seedling growth. J Oilseeds Res 28(1):47–51
Simoes MF, Antunes A, Ottoni CA et al (2015) Soil and rhizosphere-associated fungi in gray mangroves revealed by metagenomics. Genomics Proteomics Bioinformatics 13:310–320. https://doi.org/10.1016/j.gpb.2015.07.002
Tawfik E, Alqurashi M, Aloufi S, Alyamani A, Baz L, Fayad E (2022) Characterization of mutant Aspergillus niger. Sustainability 14(3):1936. https://doi.org/10.3390/su14031936
Varga J, Frisvad JC, Samson RA (2011) Aflatoxin-producing species of Aspergillus section Nigri. Stud Mycol 69:57–80. https://doi.org/10.3114/sim.2011.69.05
Vincent JM (1947) Distortion of fungal hyphae in the presence of inhibitors. Nature 159:850. https://doi.org/10.1038/159850b0
Vu D, Groenewald M, Szöke S et al (2019) DNA barcoding analysis of yeast isolates. Stud Mycol 92:135–153. https://doi.org/10.1016/j.simyco.2016.11.007
Yadav N, Malik V, Dahinwal AK, Kumari D, Saran M, Sheoran N (2024) Resistant sources against collar rot of groundnut. Indian J Agric Sci 94(10):1057–1062. https://doi.org/10.56093/ijas.v94i10.151118
Staats M, van Baarlen P, van Kan JA (2005) Molecular phylogeny of the plant pathogenic genus Botrytis and the evolution of host specificity. Molecular biology and Evolution 22(2):333–346. https://doi.org/10.1093/molbev/msi020
Author Information
Plant Pathology Department, University of Agricultural Sciences, Dharwad, India